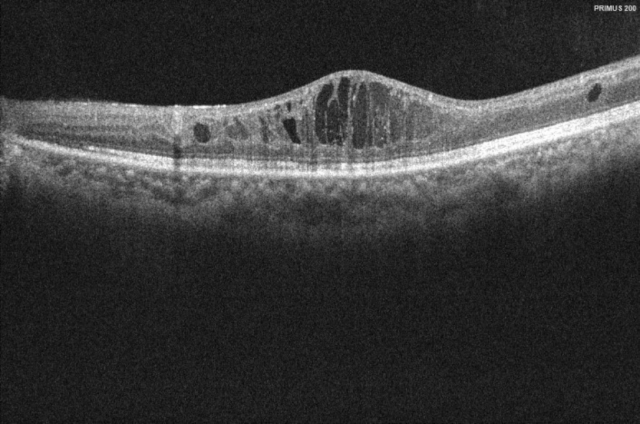
唐先生治疗前影像检查

依托“港澳药械通”政策优势,广州市第一人民医院南沙医院(下称“广州市一南沙医院”)于2023年底成功引进治疗眼底病的进口药物“布西珠单抗”,成为广州首家引进该药物的公立医院。近期,多名眼底病患者在该医院完成注射治疗,从而改善了视力,实现长效疾病控制。
唐先生治疗前影像检查
3年前,52岁的唐先生(化名)右眼视力下降明显,同时伴有眼前黑影,视物变形。经过医院检查,被确诊患有糖尿病视网膜病变。此前,他已经进行了多次第一代抗VEGF(抑制血管内皮生长因子)药物玻璃体腔注射治疗,但病情并未好转。今年春节前夕,唐先生得知广州市一南沙医院引进了“布西珠单抗”,便决定来医院进行治疗。

唐先生接受“布西珠单抗”注射治疗后,复诊结果显示其黄斑囊样水肿消退,视网膜平复。
广州市一南沙医院眼科主任邱海江为唐先生进行了“布西珠单抗”注射治疗。一个月后,唐先生来医院复查,视力由原先的4.0成为现在的4.4,视力提升了4行。
邱海江介绍,“布西珠单抗”是一种人血管内皮生长因子(VEGF)抑制剂,用于治疗以息肉灶为主要病变的老年性黄斑变性患者,以及使用常规抗人血管内皮生长因子药物或融合蛋白类药物效果不佳的患者。
“不少病情复杂的眼底病患者对第一代抗VEGF药物的反应不敏感或者需要反复注射。”邱海江说,作为治疗湿性黄斑变性和糖尿病黄斑水肿的新一代创新药物,与现有的药物相比,“布西珠单抗”能够更早地吸收视网膜内积液、视网膜下积液,在持续改善眼部解剖结构方面具有明显优势。
邱海江表示,由于“布西珠单抗”的分子量更小、穿透性更佳、解剖学改善更优,因此可以延长给药的间隔时间,患者约3~4个月注射一次即可,可以减轻患者的生活负担。
据了解,广州市一南沙医院是粤港澳大湾区“港澳药械通”第二批指定医疗机构,作为广州南沙首家港澳居民健康服务中心,该医院已经引入多款进口药物。
南方+记者 厉思璇
通讯员 魏星 黄月星